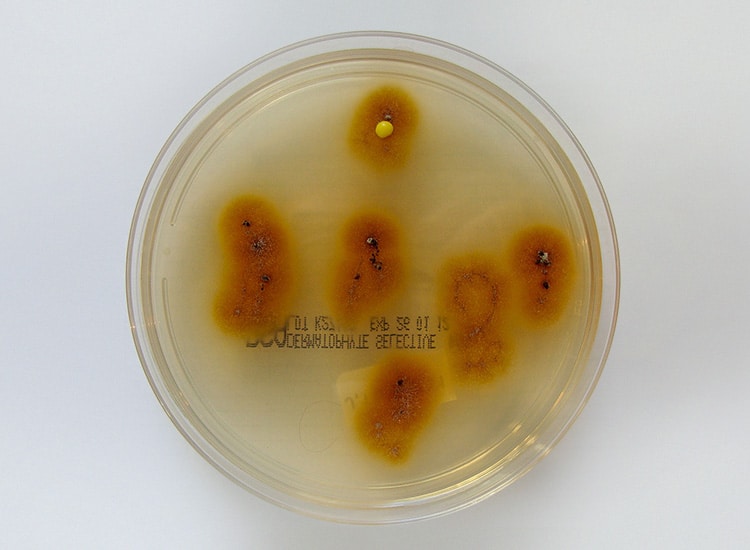

Teigne du chat : l’essentiel à savoir
✔ La teigne est une infection cutanée due à un champignon appelé Microsporum canis.
✔ Elle est très contagieuse entre animaux… et transmissible à l’Homme (zoonose).
✔ Les spores peuvent survivre plus d’un an dans l’environnement.
✔ Les chatons sont les plus souvent touchés, mais tous les chats peuvent être concernés.
✔ Un chat peut être porteur sans présenter de symptômes visibles.
✔ Le traitement doit concerner à la fois le chat et son environnement.
Définition de la teigne chez le chat
La teigne est une mycose
La teigne est une infection, appelée « mycose », une infection de la peau provoquée par des micro-champignons parasites.
Les champignons responsables de la teigne chez le chat (et également chez le chien, le lapin ou le hamster) s’appellent Microsporum canis et appartiennent au genre dermatophyte (responsable d’infections de la peau). Etant d’origine animale, on dit aussi de ces champignons qu’ils sont zoophiles.
Les champignons touchent particulièrement les chatons mais il peuvent également affecter les chats adultes.
Les champignons de développent sur la peau du chat et se nourrissent des squames et des poils, qui deviennent cassants puis tombent par touffes sur le sol.

Lésions de teigne sur les oreilles d’un chat
La teigne du chat est très contagieuse
Les champignons responsables de la teigne sont extrêmement résistants, quelque soit l’environnement, et sont très contagieux entre différentes espèces animales. Ils peuvent se transmettre de l’animal à l’humain mais en général, ne se transmettent pas d’humain à humain.
Il n’est pas forcément nécessaire de toucher un chat malade pour être contaminé par la teigne. Cela peut également se faire par les peaux ou les poils morts porteurs du parasite et présents dans l’environnement : dans le panier ou sur la brosse du chat, sur les tapis, les lits ou les sièges de voiture, sur les vêtements ou les jouets des enfants…
Les possibilités de contamination par la teigne sont donc nombreuses sachant que les spores des champignons peuvent être contagieuses pendant plus d’un an !
![]()
Symptômes de la teigne chez le chat
La teigne provoque chez le chat une perte de poils plus ou moins importante. On observe notamment des lésions à l’emporte pièce dans le pelage. Ces dernières sont généralement situées sur la face (oreilles et chanfrein), les membres et le dessus de la queue.
Des lésions plus importantes sont possibles. Les symptômes observés sont alors : la formation de croûtes et de pellicules, des rougeurs ainsi que l’apparition de violentes démangeaisons.
Attention ! Les lésions de la teigne chez le chat peuvent également mimer d’autres maladies de peau comme la démodécie,(qui est une maladie plus rare chez le chat que chez le chien) ou encore une tumeur de la peau.
Dans certains cas, un chat malade peut être asymptomatique : il est porteur du champignon mais n’a aucune lésion visible sur la peau. Cela est problématique car le chat est tout de même contagieux et peut contaminer son environnement sans être identifier comme porteur.
![]()
Quand consulter un vétérinaire ?
Une consultation est recommandée si :
• Vous observez des zones sans poils (alopécie) chez votre chat.
• Des lésions rondes apparaissent sur la peau (souvent sur la tête ou les oreilles).
• Votre chat présente des croûtes, pellicules ou rougeurs.
• Votre chat se gratte fortement ou de manière inhabituelle.
• Les lésions s’étendent ou ne guérissent pas.
• Plusieurs animaux ou membres du foyer présentent des lésions cutanées.
![]()
Diagnostic de la teigne chez le chat
Le diagnostic de la teigne chez un chat repose sur un examen des lésions mais également sur les résultats d’examen complémentaires : un examen à lampe de Wood, une observation au microscope ou encore une mise en culture des champignons parasites.
L’examen à lampe de Wood
Cet examen consiste à éclairer les zones atteintes avec une lumière ultra-violette : la lumière de Wood afin de mettre en évidence les poils contaminés par le champignon. Ces deniers présentent une fluorescence verte caractéristique.

Examen sous lumière de Wood chez un chat, mettant en évidence les poils contaminés devenant fluorescents
Cependant cet examen ne permet un diagnostic que dans 50% à 60% des cas. En effet il existe des souches de champignons ne sont pas fluorescentes et l’application de certains produits lors de soins (des lotions antiseptiques par exemple) peuvent rendre le test négatif.
L’observation au microscope
Après prélèvement de poils du chat supposés contaminés par le champignon, le vétérinaire recherche la présence de spores au microscope. Leur présence confirme alors le diagnostic.

Observation au microscope de spores Microsporum canis responsables de la teigne chez le chat
La mise en culture
Des poils du chat sont prélevés est envoyés à un laboratoire spécialisé pour une mise en culture pendant plusieurs jours. La pousse de champignons sur le prélèvement permet un diagnostic définitif et d’identifier le champignon.
Culture de champignons Microsporum Canis responsables de la teigne chez le chat
![]()
Traitement de la teigne chez le chat
Le traitement du chat
Le traitement du chat contre la teigne est impératif pour prévenir la contagion à l’Homme.
Le traitement de la teigne comprend l’utilisation de shampoings traitants ou de lotions antimycosiques et complétés, si nécessaire, par l’administration d’un médicament antifongique. Ce traitement peut s’étaler sur plusieurs semaines (entre 4 et 6 semaines), voire plusieurs mois (jusqu’à 6 mois).
Comme shampoing contre la teigne, utilisez de préférence un produit contenant de la chlorhexidine, qui s’avère être efficace contre le développement des spores de la teigne. Nous vous conseillons pour cela le shampoing Pyoderm à la chlorhexidine, des laboratoires Virbac. Le shampoing est spécialement conçu pour la peau du chat et a une action antibactérienne (il tue les bactéries) et antifongique (il tue les champignons), aidant à soigner les infections cutanées comme la teigne.
Afin de rendre le traitement encore plus efficace et éliminer d’une façon radicale les champignons, une tonte pourra être envisagée chez les chats sévèrement atteints.
Le pronostic est bon mais des rechutes sont possibles. Elles sont généralement dues à un traitement mal effectué ou arrêté trop tôt.

Chat avant et après traitement contre la teigne
Le traitement de l’environnement
Il est également nécessaire de traiter l’environnement du chat pour limiter les risques de récidives et de transmission, sachant que les spores de la teigne sont extrêmement résistants quelque soit l’environnement et la surface : le mobilier, les plantes, les vêtements…
Un traitement minutieux de l’environnement doit être effectué pendant environ trois semaines après le début du traitement médical chez le chat malade.
Traiter les pièces de l’habitat
Pour traiter votre habitat, il existe dans le commerce un purificateur d’air et de surfaces automatique, en traitement fongicide des logements d’animaux domestiques. En enclenchant le diffuseur, une brume antifongique se diffuse et va permettre d’assainir l’habitat en détruisant les spores.
Comment utiliser le purificateur :
1 • Fermez la porte et les fenêtres de la pièce à traiter et arrêtez la ventilation si vous en possédez une.
2 • Posez le purificateur sur une surface plane au milieu de la pièce.
3 • Enclenchez le diffuseur.
4 • Sortez, vous et votre chat, de la pièce.
5 • Attendez une trentaine de minutes.
6 • Aérez la pièce et laissez sécher le produit.
Il faut compter un purificateur pour une pièce de 45 m3, soit une pièce standard de 18 m2 avec une hauteur sous plafond de 2,50 m.
Le traitement peut être répété en cas de nouvelle infection.
Traiter les objets ayant été en contact avec le chat
Les jouets, les brosses de toilettage, le lieu de couchage, la litière… ainsi que toutes les surfaces ayant été en contact avec le chat (moquettes, tapis, lits, vêtements, sièges de voiture…) doivent être désinfectés avec un produit désinfectant fongicide (qui détruit les champignons). Pour cela, on peut utiliser le désinfectant fongicide de Saniterpen, qui est spécialement conçu pour traiter les espaces de vie des animaux. Une solution azotée peut également être utilisée pour les surfaces sensibles.![]() Après le traitement, les sols doivent être aspirés régulièrement et les sacs aspirateurs doivent être détruits.
Après le traitement, les sols doivent être aspirés régulièrement et les sacs aspirateurs doivent être détruits.
Traiter les vêtements et le linge
Il est impératif de désinfecter les vêtements et le linge (draps, couvertures, serviettes de toilette…) qui ont été en contact avec le chat, en les lavant à la machine.
Deux cycles sont alors nécessaires pour éliminer les spores, en utilisant une lessive désinfectante comme le désinfectant Sanytol :
• Un premier cycle à température maximale (à plus de 60°C). Pour les vêtements qui ne peuvent pas être laver à forte température, l’Assurance Maladie préconise l’utilisation d’une poudre acaricide pendant 48 heures.
• Un deuxième cycle à une température inférieure ou à froid.
• Un dernier cycle à vide est recommandé pour désinfecter les composants de la machine (tambours et tuyaux).![]()
Comment prévenir la transmission de la teigne à l’Homme ?
Il est fortement conseillé de se nettoyer minutieusement les mains après tout contact avec un chat infecté par la teigne et de ne pas laisser dormir son chat avec soi le temps du traitement.
Certains vétérinaires recommandent de confiner le chat dans une pièce de la maison (ce qui n’est pas chose facile) jusqu’à sa guérison. Il est également préférable de le manipuler avec des gants et en portant une blouse afin d’éviter tout contact avec les vêtements.
Toute personne fragilisée par une maladie ou un traitement affaiblissant le système immunitaire (malades du SIDA, personnes diabétiques ou suivant une chimiothérapie) doit impérativement éviter tout contact avec un chat infecté par la teigne.
![]()
Comment le chat transmet-il la teigne à l’humain ?
L’humain s’infeste au contact direct de poils d’un chat infecté par Microsporum canis ou par l’intermédiaire d’objets ou de lieux eux-mêmes contaminés par le dit champignon. Les femmes et les enfants sont plus sensibles.
Attention, chez le chat, il existe des porteurs sains qui peuvent également transmettre la maladie à l’Homme : en effet, certains chats peuvent porter des spores sans manifester de lésions et donc transmettre la teigne sans présenter de symptômes.
Une contamination de la teigne entre humains peut également avoir lieu mais dans ce cas ce n’est pas Microsporum canis qui est incriminé. Les champignons de la teigne d’origine humaine et donc incriminés dans la contamination d’humain à humain sont appelés dermatophytes anthropophiles. Il s’agit de Microsporum langeronii, Trichophyton soudanense, Trichophyton violaceum.
![]()
Symptômes de la teigne chez l’Homme
Il es recommandé de consulter un dermatologue si vous observez des lésions sur votre corps.
Chez l’Homme, l’infection par le champignon de la teigne provoque des lésions de la peau généralement peu graves (encore appelées herpès circiné). Ces lésions possèdent une forme circulaire. Un petit bourrelet inflammatoire (rouge foncé) entoure la lésion (voir photo).

Trois stades évolutifs de lésions de teigne sur la peau humaine
Mais le dermatophyte peut également infecter les espaces entres les doigts de pieds (intertrigo inter-orteils), les plis de l’aine (eczéma mariné de Hebra), les ongles (onychomycose).
Enfin, le champignon de la teigne chez l’Homme peut envahir les poils et les cheveux. On observe alors les symptômes suivants : formation de plaques, de croûtes et de squames (pellicules) dans les poils et les cheveux.
![]()
Questions fréquentes
La teigne du chat est-elle grave ?
Non, elle est généralement bénigne mais très contagieuse et nécessite un traitement rigoureux.
Combien de temps dure la teigne chez le chat ?
En moyenne 4 à 6 semaines, mais parfois plusieurs mois selon la gravité.
Peut-on attraper la teigne sans toucher le chat ?
Oui. Les spores peuvent survivre longtemps dans l’environnement et contaminer indirectement.
Tous les chats avec la teigne ont-ils des symptômes ?
Non. Certains chats sont porteurs sains et peuvent contaminer sans présenter de lésions.
Comment éviter la transmission à l’Homme ?
• Se laver les mains après contact
• Éviter les contacts rapprochés
• Désinfecter l’environnement
• Porter des gants si nécessaire
Faut-il isoler le chat ?
Oui, idéalement dans une pièce, le temps du traitement, pour limiter la contamination.
![]()
Produits pouvant compléter ces conseils vétérinaires
Les produits présentés ci-dessous peuvent contribuer au bien-être de votre chat en complément des conseils vétérinaires exposés dans cet article.
Ils ne remplacent en aucun cas une consultation vétérinaire lorsque celle-ci est nécessaire.

Shampoing dermatologique à la chlorhexidine pour chien et chat. Aide à purifier la peau, à nettoyer en douceur et à soutenir l’intégrité cutanée. Idéal en cas de peau sensible ou sujette aux déséquilibres, pour un usage régulier.

Diffuseur antifongique automatique : une brume se dépose et agit sur les surfaces, sans essuyage. Purifie efficacement une pièce de 18 m². Elimine les champignons responsables de la teigne et laisse un parfum frais de menthe, idéal pour les zones très touchées.

Nettoie, dégraisse et désinfecte sols et surfaces lavables, en intérieur et extérieur. Offre une action bactéricide, levuricide, fongicide et virucide pour une hygiène renforcée. Laisse une senteur mentholée fraîche et puissante après application. Sans colorant ni conservateur.

Désinfecte le linge en profondeur sans javel. Triple action : détruit les bactéries, les virus et les champignons. Actif dès 30°.

Protégez la santé de votre chat
Pour le protéger dans n’importe quelle situation, nous vous conseillons d’opter pour une assurance santé

N°1 de l’assurance santé animale
Références
Auteur de l’article
Docteur Laurence Dillière Lesseur, Vétérinaire Comportementaliste
Diplômée de l’École Nationale Vétérinaire d’Alfort.
Titulaire du Diplôme Inter-Ecoles de Vétérinaire Comportementaliste.
Cofondatrice du site Catedog.com.
Sources de l’article
• Medleau L. et Hnilica K. A. Dermatologie canine et féline atlas et guide thérapeutique. Editions Med’Com, 2008.
• Marsella R. Guide clinique de dermatologie féline. Editions Le Point Vétérinaire, 2023.
• Bensignor E., Germain P-A. et Gardini F. Guide pratique de dermatologie du chien et du chat. Editions Med’Com, 2014.
• Bensignor E. Cas cliniques de dermatologie au quotidien chiens et chats. Editions Med’Com, 2021.
Auteurs des photos
• Vincent Lesseur, web designer, graphiste, illustrateur
Cofondateur du site Catedog.com.
• Shutterstock
• Wikimedia Commons
Liens Amazon
Cet article contient des liens d’affiliation vers Amazon.
En tant que Partenaire Amazon, nous réalisons un bénéfice sur les achats remplissant les conditions requises.







